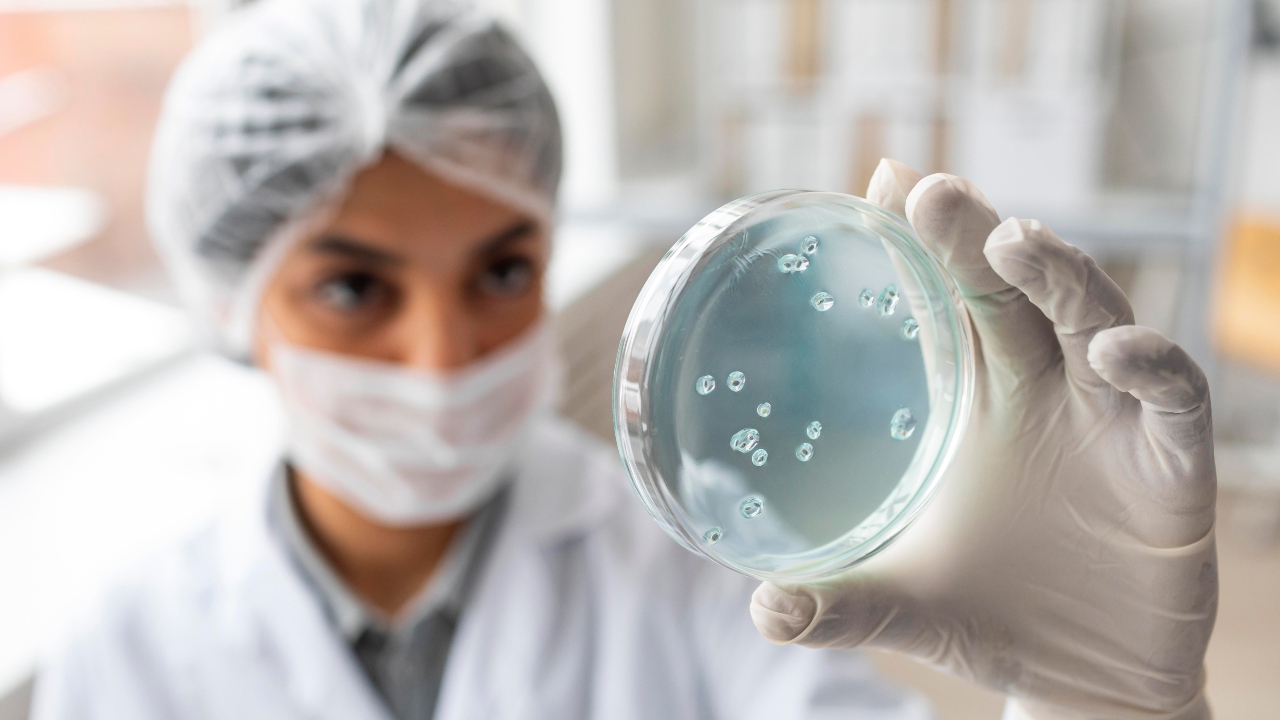

Bioethic Pharma
Comprometidos en generar valor
Estamos comprometidos con la innovación y la excelencia en la industria farmacéutica, y trabajamos arduamente para ofrecer tratamientos efectivos y accesibles para mejorar la calidad de vida de las personas.
Bioethic Pharma
Infraestructura de punta para la
distribución nacional
Experiencia comprobada
15 años de experiencia en el sector biofarmacéutico, consolidándonos como una empresa de referencia en Paraguay. La trayectoria está respaldada por alianzas estratégicas con laboratorios de renombre internacional, lo que nos permiten garantizar la distribución de productos innovadores y de alta calidad.
Logística punto a punto
Gracias a la red de transporte especializada y a un sistema de monitoreo en tiempo real, garantizamos entregas seguras y oportunas, minimizando riesgos y optimizando tiempos de respuesta. Esto nos permite abastecer a instituciones de salud como a farmacias y hospitales en el país.
Sector privado
Trabajamos estrechamente con el sector privado para brindar asesoramiento técnico y garantizar el abastecimiento continuo, contribuyendo al desarrollo de la atención médica en Paraguay con soluciones innovadoras y efectivas, respaldadas por la garantía de laboratorios de prestigio.
Áreas Terapéuticas
Contamos con una amplia gama de productos de alta calidad para satisfacer las necesidades de nuestros pacientes. Estamos comprometidos con la innovación y la excelencia en la industria farmacéutica para ofrecer tratamientos efectivos y accesibles para mejorar la calidad de vida de las personas.
Ver todosAnestesia
Antiviral
Cardiología
Dermocosmetica
Diabetes
Dispositivos médicos
Endocrinología
Flebología
Gastroenterología
Ginecología
Hematología
Infectología
Neurología
Obstetricia
Oncología
Psiquiatría
Reumatología
Trasplante
Traumatología
Urología
Pediatría
Nefrología
Anestesia
Productos para el área de Anestesia.

Antiviral
Productos para el área de Antiviral.

Cardiología
Productos para el área de Cardiología.

Dermocosmetica
Productos para el área de Dermocosmetica.

Diabetes
Productos para el área de Diabetes.

Dispositivos médicos
Productos para el área de Dispositivos médicos.

Endocrinología
Productos para el área de Endocrinología.

Flebología
Productos para el área de Flebología.

Gastroenterología
Productos para el área de Gastroenterología.

Ginecología
Productos para el área de Ginecología.

Hematología
Productos para el área de Hematología.

Infectología
Productos para el área de Infectología.
Neurología
Productos para el área de Neurología.

Obstetricia
Productos para el área de Obstetricia.

Oncología
Productos para el área de Oncología.

Psiquiatría
Productos para el área de Psiquiatría.

Reumatología
Productos para el área de Reumatología.

Trasplante
Productos para el área de Trasplante.

Traumatología
Productos para el área de Traumatología.

Urología
Productos para el área de Urología.

Pediatría
Productos para el área de Pediatría.

Nefrología
Productos para el área de Nefrología.

Cumplimos con normativas internacionales para garantizar la pureza, estabilidad y efectividad de cada fármaco.
- Medicamentos innovadores
- Genéricos avanzados
- Biosimilares


Bioethic Pharma
Nuestro propósito
Ofrecer a la comunidad médica y farmacéutica del país medicamentos innovadores, altamente efectivos y seguros, que mejoren la calidad de vida de las personas, logrando un crecimiento sostenido tanto en el sector público como en el privado.
Investigación
Seguridad
Informaciormaciones



























